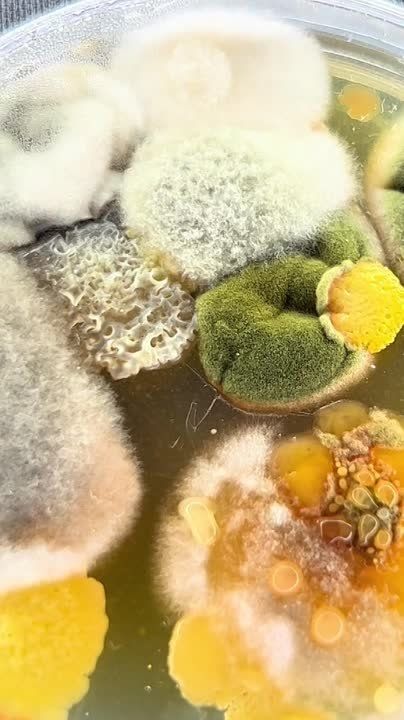
�������� ������� �������, ������� ������� � ����������, ��� �����������

Ещё пара жалоб из Приднестровья в Москву, и в Молдавию полетят "Искандеры". Об этом сообщил журналистам высокопоставленный сотрудник молдавских спецслужб. #Приднестровье @new_militarycolumnist // Военный обозреватель
Новости за 02.03.2024
Тиктокер показал попкорн, который уронили в кинотеатре, под микроскопом. Автор ускорил рост грибка с помощью раствора и инкубатора. Результат убил.Правило пяти секунд явно не работает.
Авторские размышления о том, где и как можно пережить полосу серую или даже черную, об отдушине, убежище, передышке — в эссе «Мое личное убежище».
Главные события на 15:00:Путин поздравил Лукашенко с проведением выборовХуснуллин пообещал восстановить АвдеевкуИноагент Пивоваров распустил свою команду из РФСнайпер «Шика» уничтожил целое отделение ВСУВ...
Молдавия и Приднестровье могут объединиться, считает президент Республики Майя Санду. По ее словам, сейчас страна стоит на распутье. Однако начало переговоров о вступлении в Евросоюз может объединить Кишинев и...
В Китае первое беспилотное аэротакси уже берет заказы: «Китайское аэротакси AutoFlight впервые совершило междугородний перелет (Шэньчжэнь-Чжухай) в полностью беспилотном режиме. Отрезок в 50 км по прямой аппарат преодолел за 20 минут, а поездка на...
КИШИНЕВ, 2 марта. /ТАСС/. Партия социалистов Республики Молдова призвала Кишинев и Тирасполь активизировать переговоры и не допустить эскалации в отношениях. С обращением оппозиционная партия выступила по случаю годовщины вооруженного конфликта на...
Так с танцами и на позитиве бежит ультрамарафон легкоатлетка из Тирасполя Светлана Шепелёва. 380 км по Азербайджану64 атлета из разных стран стартовали 29 февраля. 4 марта прибегут в Баку
В редакцию приходят письма от неравнодушных читателей. Воспоминания о своем детстве прислала Надежда Владимировна Гарага из села Фрунзе Слободзейского района. Посчитав эти воспоминания и душевными, и любопытными, такими, которые могут откликнуться в...
В Дубоссарах почтили память погибших защитников Приднестровья. 32 года назад в ночь на 2 марта начался военный конфликт на Днестре. В народе эту дату называют «Чёрный мэрцишор». Сегодня горожане возложили цветы почтили память погибших.
Президент Молдавии Майя Санду считает, что начало переговоров о вступлении страны в ЕС открывает возможность для объединения двух берегов Днестра. Об этом политик заявила в годовщину начала Приднестровского конфликта.В субботу, 2...
КИШИНЕВ, 2 мар - РИА Новости. Кишинев и Тирасполь должны сесть за стол переговоров, чтобы найти мирное решение конфликта и не допустить его превращения в военное противостояние, считает оппозиционная в Молдавии Партия социалистов. Депутаты...
Санду заявила об историческом шансе на воссоединение Молдавии с ПриднестровьемПрезидент Молдавии Майя Санду заявила, что у страны появился «исторический шанс» на воссоединение с Приднестровьем. Поводом для этого, по...
ТИРАСПОЛЬ, 2 мар – РИА Новости. Председатель Верховного Совета (парламента) непризнанной Приднестровской Молдавской Республики Александр Коршунов отметил вклад российских миротворцев, которые помогли остановить конфликт 1992 года на Днестре. "Хочу...
Президент Молдавии Майя Санду в годовщину вооруженного конфликта на Днестре заявила, что начало диалога с Брюсселем о членстве в Европейском союзе – это отличный шанс, чтобы урегулировать кризисную ситуацию с Приднестровьем и вместе вступить в...
Новые марки-ромбы. Это пятая серия «Породы кошек». На марках: экзотическая короткошёрстная, мейн-кун, домус (домашняя обыкновенная), британская короткошёрстная.Серию гасили сегодня в Тираспольском объединённом музее.
У каждой вещи своя харизма. В рубрике «Житейские перекрестки» читайте удивительную историю о встрече двух людей. «Кардиган» — вязаный свитер и человек. В духе всенародно любимой киноленты.
СЕМЕЙНЫЙ БЮДЖЕТ – как спланировать так, чтобы хватило на всеЧто такое семейный бюджет и чем он может помочь? В этой кажущейся простой, но актуальной для каждой семьи теме нам помог разобраться декан экономического факультета ПГУ - Иван...
Цветы возлагали этим утром на дубоссарском Мемориале Славы. 32 года назад молдавский ОПОН напал на город. В результате атаки был смертельно ранен начальник местной милиции майор Игорь Сипченко. У памятного знака в его честь также состоялся митинг.